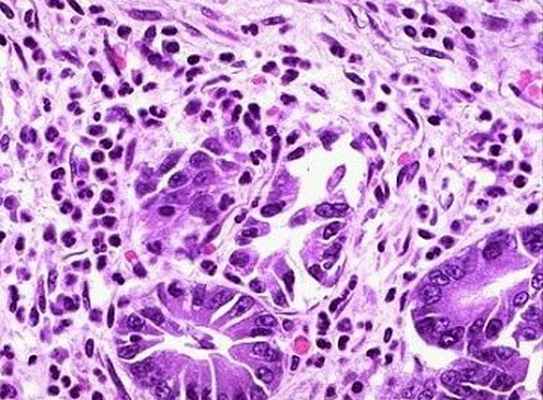

Аутоиммунный метапластический атрофический гастрит
Добавил пользователь Валентин П. Обновлено: 07.01.2026
Для цитирования: Щелоченков С.В., Гуськова О.Н., Колбасников С.В., Бордин Д.С. Аутоиммунный гастрит: нерешенные вопросы диагностики, значение внутрипросветной эндоскопии // Эффективная фармакотерапия. 2021. Т. 17. № 4. С. 76–81.
- Аннотация
- Статья
- Ссылки
- Английский вариант
Аутоиммунный гастрит остается недостаточно изученным заболеванием с неустановленной распространенностью и неспецифической клинической картиной. Для аутоиммунного гастрита характерны ассоциация с другими аутоиммунными заболеваниями и повышенный риск развития нейроэндокринных и эпителиальных опухолей желудка. Диагностические критерии аутоиммунного гастрита четко не определены, диагноз основывается на выявлении специфических антител и морфологической верификации, при этом значение внутрипросветной эндоскопии не установлено.
В статье описаны характерные признаки аутоиммунного гастрита, выявляемые при рутинном эндоскопическом исследовании и с применением увеличительной и узкоспектральной визуализации, представлено клиническое наблюдение.
- КЛЮЧЕВЫЕ СЛОВА: гастрит, метаплазия, опухоль желудка, рак желудка, Helicobacter pylori, пепсиноген, анемия, гипергастринемия, эндоскопия, Сиднейская система, OLGA
Аутоиммунный гастрит остается недостаточно изученным заболеванием с неустановленной распространенностью и неспецифической клинической картиной. Для аутоиммунного гастрита характерны ассоциация с другими аутоиммунными заболеваниями и повышенный риск развития нейроэндокринных и эпителиальных опухолей желудка. Диагностические критерии аутоиммунного гастрита четко не определены, диагноз основывается на выявлении специфических антител и морфологической верификации, при этом значение внутрипросветной эндоскопии не установлено.
В статье описаны характерные признаки аутоиммунного гастрита, выявляемые при рутинном эндоскопическом исследовании и с применением увеличительной и узкоспектральной визуализации, представлено клиническое наблюдение.
По современным представлениям, аутоиммунный гастрит (АИГ) – хроническое иммуноопосредованное заболевание, при котором происходит поражение преимущественно клеток слизистой оболочки тела и дна желудка, характеризующееся развитием двух основных типов аутоантител: антител к париетальным клеткам желудка (АПКЖ) и антител к внутреннему фактору Касла [1]. В 15–20% случаев АИГ приводит к развитию пернициозной анемии, или болезни Аддисона – Бирмера, отличающейся дефицитом витамина B12. Установлена тесная этиопатогенетическая связь между АИГ и другими аутоиммунными заболеваниями [2]. Гипергастринемия, возникающая в результате разрушения париетальных клеток, гипохлоргидрия или ахлоргидрия увеличивают риск эпителиальных и нейроэндокринных опухолей, в связи с чем необходимы своевременная диагностика АИГ и надлежащее последующее наблюдение.
Распространенность АИГ точно не установлена, но считается относительно низкой, что можно объяснить недостаточной и трудоемкой диагностикой и отсутствием клинических проявлений на ранних стадиях. Помимо этого, АИГ во многих случаях протекает под маской Helicobacter pylori-индуцированного атрофического гастрита [3]. Как и другие аутоиммунные заболевания, АИГ чаще встречается у женщин, чем у мужчин: в соотношении 3:1, по данным [2]. Аутоиммунный гастрит обычно диагностируется с использованием комбинации лабораторных и гистологических критериев. Значение эндоскопии изучено недостаточно, но развитие методов оптической и цифровой визуализации может в корне изменить подходы к выявлению и последующему наблюдению пациентов с АИГ.
АИГ и другие аутоиммунные заболевания
Установлено, что АИГ ассоциируется с такими аутоиммунными состояниями, как аутоиммунный тиреоидит, болезнь Аддисона [4], хроническая спонтанная крапивница [5], сахарный диабет 1-го типа [6], миастения, витилиго [7]. В некоторых исследованиях также упоминаются воспалительные заболевания кишечника, системная красная волчанка и аутоиммунная гемолитическая анемия [8].
Впервые связь между АИГ и аутоиммунным заболеванием щитовидной железы была описана в 1960 г. и получила название «тиреогастральный синдром». По мере накопления данных эта связь была охвачена полигландулярным аутоиммунным синдромом типа IIIb (АПС IIIb). Основное заболевание АПС IIIb – аутоиммунный тиреоидит, сочетающийся с одним или несколькими аутоиммунными заболеваниями, не связанными с щитовидной железой. Исключение составляют болезнь Аддисона и гипопаратиреоз, поскольку указанные заболевания идентифицируют полигландулярные аутоиммунные синдромы 1 и 2 соответственно [9, 10].
Полигландулярный аутоиммунный синдром типа IIIb включает аутоиммунные заболевания желудка и кишечника (хронический атрофический гастрит, целиакию, хронические воспалительные заболевания кишечника), а также аутоиммунные заболевания печени (аутоиммунный гепатит, первичный билиарный цирроз). По различным данным, от 10 до 40% пациентов с тиреоидитом Хашимото имеют ассоциированные желудочные расстройства. В исследовании [11] у 320 пациентов с АИГ ассоциированные аутоиммунные заболевания выявлялись в 53,4% случаев, преимущественно в форме аутоиммунного тиреоидита у 116 (36,2%) пациентов.
Встречаемость АИГ увеличивается в три – пять раз у пациентов с сахарным диабетом 1-го типа, достигая 5–10%. В проведенном Диабетологическим центром Вашингтонского университета исследовании проанализировано более 1200 пациентов с сахарным диабетом 1-го типа. Частота и распространенность сопутствующих аутоиммунных расстройств увеличивались с возрастом, а женский пол во многом ассоциировался с сопутствующими аутоиммунными расстройствами [6]. Помимо заболеваний щитовидной железы и коллагенозов АИГ с развитием пернициозной анемии был одним из наиболее частых сопутствующих аутоиммунных заболеваний у пациентов с диабетом 1-го типа [12].
АИГ и H. pylori-ассоциированный атрофический гастрит
В многочисленных исследованиях установлено, что длительное присутствие у пациента H. pylori, как и АИГ, приводит к развитию атрофического пангастрита. Кроме того, у многих пациентов с АИГ выявляется инфекция H. pylori [13]. Также описано развитие H. pylori-позитивного гастрита до АИГ, этиология этого процесса, предположительно, связана с антигенной мимикрией или перекрестной реактивностью [14].
Установлено, что у части пациентов с H. pylori вырабатывается широкий спектр антител, включая антифовеолярные, антиканаликулярные и АПКЖ, характерные для АИГ. Наиболее часто обнаруживаются антиканаликулярные антитела, которые, как и АПКЖ, направлены против H + /K + -АТФазы [15].
Несмотря на схожесть в течении указанных типов гастрита, необходимо дифференцировать АИГ от H. pylori-ассоциированного гастрита. Для АИГ в первую очередь характерно избирательное поражение слизистой оболочки тела и дна желудка, где сосредоточена основная масса париетальных клеток – мишеней аутоантител при АИГ. В то же время поражения, вызванные H. pylori, имеют мультифокальный характер с преимущественным и первичным вовлечением антрального отдела желудка [16].
Дифференцировать АИГ и вызванный H. pylori гастрит возможно по другим отличительным признакам: гипергастринемии, развивающейся в результате гиперплазии энтерохромаффиноподобных клеток; псевдогипертрофии париетальных клеток (редко наблюдается при инфекции H. pylori, но может развиваться при длительном применении препаратов из группы ингибиторов протонной помпы); поражении фундальных желез. Воспалительные изменения в слизистой оболочке желудка характерны для обоих типов гастрита, но имеют ряд отличительных черт. Для АИГ характерна инфильтрация собственной пластинки лимфоцитами и плазматическими клетками с вовлечением глубоких слоев, тогда как для атрофического гастрита, вызванного H. pylori, типичны поверхностные поражения с активным воспалением [17].
Полезным может быть определение таких лабораторных показателей, как гастрин 17 (гипергастринемия характерна для АИГ, редко встречается при H. pylori-ассоциированном гастрите) и уровень пепсиногена I (низкий при АИГ, нормальный – при инфекции H. pylori на стадиях до диффузной атрофии с вовлечением слизистой оболочки тела и дна желудка).
Эндоскопическая характеристика АИГ
До последнего времени роль внутрипросветной эндоскопии в диагностике АИГ ограничивалась в основном получением биопсийного материала для морфологического исследования. Считалось, что в плане диагностики АИГ эндоскопический метод имеет ряд существенных ограничений: низкая чувствительность и специфичность, значительная вариабельность интерпретации визуальных изменений слизистой оболочки между врачами-эндоскопистами, которая определяется квалификацией специалиста и уровнем эндоскопического оборудования [18]. С развитием эндоскопических технологий, появлением аппаратуры с высоким разрешением, увеличительной эндоскопии, узкоспектральной и автофлуоресцентной визуализации стало возможно выявлять минимальные атрофические изменения слизистой оболочки желудка, что существенно повлияло на диагностику АИГ.
В недавно опубликованном многоцентровом японском исследовании [19] в качестве критериев диагностики АИГ помимо наличия специфических антител, пернициозной анемии и гипергастринемии сформулирован такой критерий, как «эндоскопически определяемый атрофический гастрит с преимущественной локализацией в теле желудка». Всем указанным диагностическим признакам соответствовало 245 пациентов из 11 медицинских учреждений Японии. Обследуемые прошли тщательное эндоскопическое исследование. Выполнена фотофиксация, оценка визуальных изменений проводилась тремя эндоскопистами независимо друг от друга, заключения формировались на основании консенсуса. Необходимо отметить, что часть исследований проводилась на оборудовании без функций увеличения и осмотра в узком спектре света, при этом ведущие эндоскопические признаки были четко идентифицированы.
Критерий «эндоскопически определяемый атрофический гастрит с преимущественной локализацией в теле желудка» определен как обесцвеченная, тусклая слизистая оболочка с хорошо визуально различимыми сосудами, наблюдаемая не только на малой кривизне, но и на всей поверхности большой кривизны (открытый тип атрофии O-p по классификации Kimura – Takemoto [20]), в отсутствие или при минимально выраженной атрофии слизистой оболочки в антральном отделе. Кроме указанного критерия, оценивались и другие эндоскопические изменения в слизистой оболочке тела желудка: островки неповрежденной слизистой в своде желудка, свойства слизи, а также рассеянные выступающие мельчайшие белесоватые участки.
При анализе результатов исследования [19] выявлено, что наиболее частым эндоскопическим проявлением АИГ служит наличие атрофических изменений с преимущественной локализацией в теле желудка. Превалировал тип O-p (90%), реже встречались пациенты с типами O-1, O-2, O-3 (суммарно 6%), у 4% обследованных не удалось четко определить распространенность атрофии слизистой оболочки. Другие эндоскопические признаки атрофии выявлялись примерно у трети пациентов. Визуальные изменения слизистой оболочки достоверно коррелировали с морфологической картиной.
Клинический случай
Наши наблюдения соответствуют исследованию [19]. Приведем клинический пример. К гастроэнтерологу на амбулаторном приеме обратилась пациентка 44 лет с жалобами на тяжесть, чувство переполнения в эпигастральной области после еды, чувство раннего насыщения, практически постоянную тошноту, неприятный запах изо рта, а также боли спастического характера в гипогастральной области, метеоризм и кашицеобразный, мажущий стул до трех раз в сутки. Указанные жалобы больная отмечала в течение последних двух лет, ранее не обследовалась и не лечилась, наблюдалась у эндокринолога в связи с первичным гипотиреозом в исходе аутоиммунного тиреоидита, получала терапию левотироксином.
При объективном обследовании: пониженное питание (индекс массы тела по Кетле 16,0 кг/м 2 ), кожные покровы и видимые слизистые умеренно бледные, язык влажный, слегка обложен белым налетом, живот при пальпации мягкий, умеренно болезненный в мезогастральной области и по левому фланку, больше в левой подвздошной области. По другим органам и системам без особенностей.
По результатам осмотра рекомендовано обследование, в том числе эзофагогастродуоденоскопия (ЭГДС) с выполнением уреазного теста на H. pylori. По данным ЭГДС (рис. 1) выявлены эндоскопические признаки атрофии слизистой оболочки желудка с преимущественной локализацией в теле: тусклая, истонченная слизистая с выраженным сосудистым рисунком, типичные складки практически отсутствовали, спрямлены, в просвете вязкая мутная слизь с желчью в небольшом количестве. По классификации Kimura – Takemoto изменения соответствовали открытому типу атрофии О-р. Слизистые оболочки антрального отдела, пищевода и двенадцатиперстной кишки не изменены (рис. 1), уреазный тест на H. pylori отрицательный.
В связи с полученными данными пациентке рекомендовано расширенное обследование: анализы крови на сывороточные пепсиногены I и II, гастрин 17, цианокобаламин, АПКЖ, IgG к H. pylori, а также биопсия слизистой оболочки по Сиднейской системе с последующей морфологической оценкой по OLGA.
По результатам обследования (табл. 1) выявлены характерные для АИГ лабораторные признаки: гипергастринемия, положительные АПКЖ, снижение уровня В12 в сочетании с низкими значениями пепсиногена I и соотношения пепсиногенов I/II.
Результаты морфологического исследования подтвердили и дополнили клинико-лабораторные и эндоскопические данные (табл. 2), отмечена неполная (толстокишечная) метаплазия слизистой оболочки тела желудка (рис. 2). Согласно руководству по лечению предраковых состояний и поражений эпителия желудка (MAPS II), неполный тип кишечной метаплазии ассоциируется с бóльшим риском развития рака желудка (РЖ), чем тонкокишечный (полный) тип, и сопоставим с риском в случаях обширной атрофии слизистой или отягощенного по РЖ семейного анамнеза [21].
Приведенное клиническое наблюдение наглядно демонстрирует важность эндоскопического исследования для выявления пациентов с АИГ и стратификации риска развития РЖ у данной группы больных. Вместе с тем необходимо отметить, что в рассмотренном примере так же, как и в исследовании [19], представлены случаи с выраженными визуальными изменениями слизистой оболочки. Обнаружение ранних признаков АИГ – приоритетная задача, решение которой, по-видимому, возможно только с применением увеличительной эндоскопии и осмотром слизистой в узком спектре света, а также с учетом пересмотра используемых диагностических критериев.
По наблюдениям T. Kotera и соавт. [22], одним из ранних признаков атрофии при АИГ, выявляемым при эндоскопическом исследовании (до стадии визуально различимой атрофии в теле желудка), могут служить псевдополипоидные красноватые узелки, располагающиеся по большой кривизне, которые при гистологическом исследовании характеризуются очаговой атрофией с сохранением фундальных желез и псевдогипертрофией париетальных клеток.
В работе [23] с помощью увеличительной эндоскопии изучены характерные изменения микрососудистой картины слизистой оболочки желудка при АИГ. Микрососуды слизистой оболочки желудка включают два основных компонента: субэпителиальную капиллярную сеть, вид которой различается в зависимости от отдела желудка (полигональная – в теле, спиралевидная – в антруме), и собирательные венулы (в теле имеют регулярное расположение, в антруме наблюдаются редко). Авторы исследования [23] установили, что при АИГ в антральном отделе желудка микрососуды имели типичную спиралевидную субэпителиальную капиллярную сеть в отличие от микрососудов слизистой оболочки тела желудка, которые характеризовались потерей нормальной полигональной формы с нерегулярно расположенными собирательными венулами. Полученные данные могут быть полезны для дифференциальной диагностики АИГ и H. pylori-ассоциированного атрофического гастрита.
В другом исследовании [24] с применением увеличительной эндоскопии изучались особенности ямочного рисунка слизистой оболочки желудка. Установлено, что визуально различимая атрофия слизистой оболочки тела желудка при АИГ имеет характерный вид – близко расположенные небольшие овальные ямки, отличающиеся от атрофического гастрита, вызванного инфекцией H. pylori.
Визуальные изменения слизистой оболочки желудка при АИГ целесообразно оценивать по совокупности признаков, что существенно повышает чувствительность и специфичность эндоскопического метода.
В клинической практике АИГ, заболевания со множеством нерешенных вопросов, сложилась неоднозначная и даже парадоксальная ситуация. С одной стороны, доказано, что АИГ характеризуется повышенным риском нейроэндокринных и эпителиальных опухолей желудка, соответственно необходимы ранняя диагностика, стратификация риска и последующее систематическое наблюдение. С другой стороны, нет четких критериев диагностики данного заболевания, следовательно, у части пациентов АИГ устанавливается на стадии сформированной диффузной атрофии слизистой оболочки, а в некоторых случаях даже ретроспективно, когда выявляется злокачественное новообразование желудка.
Из-за сложностей диагностики АИГ, которая базируется на дорогостоящих лабораторных и морфологических методах, формируется ложное представление о том, что заболевание встречается с невысокой частотой, хотя исследования последних лет свидетельствуют об обратном, особенно в когорте пациентов с другими аутоиммунными заболеваниями.
За последнее десятилетие возможности внутрипросветной эндоскопии значительно выросли. По многим заболеваниям и патологическим состояниям в корне пересмотрены рекомендации по диагностике и наблюдению методами эндоскопии. Созданы классификации и диагностические критерии, позволяющие по визуальным признакам с высоким уровнем достоверности выявлять предраковые изменения слизистой оболочки желудка. По проблеме изучения АИГ также появились публикации, в которых определены типичные изменения слизистой при данном заболевании, в том числе на ранних стадиях.
До 2019 г. не было разработано рекомендаций по эндоскопическому наблюдению за пациентами с АИГ. В 2019 г. в MAPS II [21] были обновлены рекомендации по диагностике и ведению пациентов с кишечной метаплазией и атрофическим гастритом. В систематический обзор литературы вошел также АИГ. Согласно МАРS II, пациентам с АИГ рекомендовано эндоскопическое наблюдение каждые 3–5 лет для оценки эпителиальной дисплазии, карциноидных опухолей и аденокарциномы желудка. Эрадикационная терапия H. pylori показана всем пациентам с неатрофическим хроническим гастритом и АИГ [21].
Рекомендации по ведению пациента с хроническим гастритом для профилактики рака желудка. Аутоиммунный гастрит: как поставить диагноз до развития пернициозной анемии
Татьяна Львовна Лапина, доцент, кандидат медицинских наук:
— Спасибо большое, Владимир Трофимович, Оксана Михайловна. Для меня большая честь выступить сегодня первой на замечательной ХХХ сессии «Интерниста».
Из цикла трех лекций это моя последняя лекция. В основном, будет сделан упор на такую форму гастрита, которую, на мой взгляд, мало распознают практикующие врачи. Это аутоиммунный гастрит.
Аутоиммунный гастрит – воспаление слизистой оболочки желудка, обусловленное аутоиммунным механизмом. Естественно, характерным морфологическим признаком этого аутоиммунного процесса служит атрофия фундальных желез с кишечной метаплазией.
К сожалению, диагноз аутоиммунного гастрита считается диагнозом научным, редким. Действительно, в рутинной клинической практике редко когда доступно проведение анализа на наличие тех самых антител, которые лежат в основе постановки диагноза аутоиммунного гастрита.
Но не нужно думать, что аутоиммунный гастрит – это некий миф среди наших пациентов. Он встречается достаточно часто и имеет очень большое клиническое значение.
Я постараюсь это доказать.
Действительно, говорить о том, что частота аутоиммунного гастрита известна, наверное, не приходится. Есть усредненные данные, в том числе, из руководства Шлезингера (Sleisenger) и Фортрана (Fordtran) по гастроэнтерологии – классической нашей книжки-учебника по гастроэнтерологии.
На долю аутоиммунного гастрита приходится 5% среди всех случаев гастрита. Однако, если говорить об отдельных работах, частота аутоиммунного гастрита в популяции может оцениваться от 0,5% до 2%. С возрастом этот процент может существенно увеличиваться.
Аутоиммунный гастрит обусловлен образованием антител. Антител к двум структурам. Первая структура очень хорошо известна практикующим врачам благодаря тому, что есть класс лекарственных препаратов «ингибиторы протонной помпы (ИПП)».
Они ингибируют протонную помпу или H-калиевую АТФазу париетальных клеток слизистой оболочки желудка. Первый класс известных антител при аутоиммунном гастрите направлен как раз против H-калиевой АТФазы.
Есть класс антител, которые направлены против фактора Касла, необходимого для нормального усвоения витамина B12.
Для того чтобы не быть голословной, я представляю морфологические препараты, которые с помощью флюоресценции и иммуногистохимии окрашены и показывают те самые антитела, которые являются причиной аутоиммунного гастрита.
В чем актуальность аутоиммунного гастрита? В первую очередь, в том, что это гастрит атрофический. А атрофический гастрит – это предраковое заболевание. При аутоиммунном гастрите риск рака желудка достоверно увеличен в 3-6 раз.
Еще один аспект, который делает проблему раннего диагноза аутоиммунного гастрита очень важной. Все дело в том, что с аутоиммунным гастритом человечество столкнулось впервые, не зная, что это аутоиммунный гастрит.
В XIX веке Аддисон (Addison) и Бирмер (Biermer) описали смертельно-опасную злокачественную анемию. Лишь впоследствие оказалось, что страдает тот самый фактор Касла, который необходим для нормального усвоения витамина B12.
Сейчас аутоиммунный гастрит несет в себе высокий риск развития тяжелой пернициозной анемии. Она и в наше время может протекать тяжело и нести угрозу для жизни пациента.
Если вы видите пациента с низким гемоглобином, высоким световым показателем, большим объемом эритроцита, низким уровнем сывороточного цианокобаламина, наверное, диагноз аутоиммунного гастрита у вас будет уже практически в руках.
Очень интересно, но следует сказать о следующем моменте, который, как правило, не известен широкой аудитории практикующих врачей. Все дело в том, что мы связываем аутоиммунный гастрит с B12-дефицитной анемией. А на самом деле аутоиммунный гастрит может быть связан и с железодефицитной анемией. До 20-30% больных железодефицитной анемией без ее очевидных причин (например, недавнее желудочно-кишечное кровотечение) могут иметь аутоиммунный гастрит.
В чем дело? Если теряются железы желудка, наступает гипохлоргидрия. В этих условиях гипохлоргидрии не происходит перехода двухвалентного железа в трехвалентное. Не происходит адекватной денатурации белка с освобождением железа, связанного с белками. Усвоение железа нарушается. Это ведет к железодефицитной анемии.
На самом деле, особенности аутоиммунного гастрита на этом не исчерпываются.
Гипохлоргидрия по механизму отрицательной обратной связи приводит к гипергастринемии. Активно начинают функционировать клетки, которые называются энтерохромаффиноподобными клетками, в ответ на высокий уровень гастрина. Если они активно функционируют, они могут подвергаться гиперплазии.
Какая опухоль исходит из раздраженных энтерохромаффиноподобных клеток? Это карциноидная опухоль. Значит, своевременно ставить диагноз аутоиммунного гастрита имеет смысл и потому, что мы таким образом активно формируем группу наблюдения пациентов с высоким риском развития карциноидных опухолей.
Среди известной популяции пациентов с карциноидной опухолью 85% имели доказанный аутоиммунный гастрит.
Еще одна очень интересная клиническая особенность аутоиммунного гастрита – частая связь этого заболевания с другими аутоиммунными заболеваниями. В первую очередь, поражением щитовидной железы.
У четверти пациентов с аутоиммунным поражением щитовидной железы, аутоиммунным тиреоидитом, обнаруживаются антитела к париетальным клеткам. Еще более часто антитела к париетальным клеткам обнаруживаются при Аддисоновой болезни. Часто они встречаются у пациентов с сахарным диабетом 1-го типа и у пациентом с витилиго.
Как нам действительно поставить рано диагноз аутоиммунного гастрита? Нам очень хорошо помогает простой метод, простой анализ крови, который, наверное, сейчас доступен в самых разных регионах России. Это определение уровня сывороточного пепсиногена.
Низкий сывороточный пепсиноген и низкое соотношение пепсиногена-1/пепсиногена-2 свидетельствует об атрофии тела желудка. Это серологический маркер морфологического, гистологического изменения слизистой оболочки желудка, а именно атрофии.
Очень часто к нам в клинику приходят больные с аутоиммунным гастритом, имея на руках низкие показатели сывороточного пепсиногена-1, высокий показатель сывороточного гастрина. Их это тревожит. Мы понимаем, что, скорее всего, если проведем анализ на антитела к париетальным клеткам, мы получим в данной ситуации положительный результат.
Как поставить диагноз аутоиммунного гастрита до развития пернициозной анемии?
Низкие значения сывороточного пепсиногена.
Гипергастринемия пускай не уводит вас в сторону поиска Золлингера-Эллисона. В первую очередь подумайте о наличии аутоиммунного гастрита.
Высокий цветовой показатель.
Родственники больных с доказанным диагнозом аутоиммунного гастрита.
Пациенты с аутоиммунным заболеванием (в первую очередь, с аутоиммунным тереоидитом).
Наконец, нельзя сказать, что пилорический хеликобактер имеет непосредственное отношение к аутоиммунному гастриту. Доказано, что пилорический хеликобактер отличается так называемой антигенной мимикрией. Ряд молекулярных структур пилорического хеликобактера могут напоминать H-калиевую АТФазу париетальных клеток, ее альфа-домен.
Именно когда иммунная система человека реагирует антителами на пилорический хеликобактер, начинает страдать, соответственно, тот самый фермент, который находится в париетальных клетках слизистой оболочки желудка. Поэтому невозможно говорить об аутоиммунном гастрите в отрыве от понимания инфекции пилорического хеликобактера.
Вы, наверное, были свидетелями замечательного выступления профессора Питера Малфертайнера (Peter Malfertheiner), которое было доступно нашей аудитории благодаря сообществу «Интернист». Мне очень приятно впервые в этой интернет-аудитории сказать о том, что вышли 4-е Маастрихтские рекомендации уже в виде официального опубликованного доклада. Огромное значение в этом докладе уделяется профилактике рака желудка.
Эксперты с высокой степенью уверенности говорят нам о том, что инфекция пилорического хеликобактера – наиболее доказанный фактор риска рака желудка. Именно эрадикация пилорического хеликобактера служит самой многообещающей стратегией для снижения заболеваемости раком желудка.
Как мы можем выделить необходимую группу, чтобы проводить скрининг рака желудка? Это те самые серологические маркеры атрофии. Например, низкий пепсиноген, о котором мы сегодня с вами говорили.
Естественно, каким больным мы будем говорить о проведении эрадикационной терапии для профилактики рака желудка?
Это родственники больных раком желудка, больные с неоплазией после эндоскопической или субтотальной резекции желудка.
Обратите внимание, очень актуально для нашей сегодняшней темы: больные с гастритом. В том числе гастрит с преимущественным поражением тела желудка, гастрит с выраженной атрофией.
Наконец, как аутоиммунный гастрит вошел в 4-й Маастрихтский консенсус. Есть специальное утверждение. Оно говорит о том, что предраковое изменение высокого риска требует регулярного эндоскопического наблюдения.
Нам нужно проведение клинических исследований, которые бы четко показали, в каком правильном временном режиме нам нужны эти наблюдения. В качестве специальной группы, которая должна подвергаться такому активному наблюдению, активному ведению, специально выделяются пациенты с пернициозной анемией и доказанным аутоиммунным гастритом.
Естественно, Российская гастроэнтерологическая ассоциация откликнулась на новые веяния в мировой гастроэнтерологии. Мы даем очень широкое показание для проведения эрадикационной терапии. По сути, Российская гастроэнтерологическая ассоциация называет гастрит как возможное показание для проведения эрадикационной терапии.
Как мы будем проводить эрадикационной терапию? С помощью стандартной тройной терапии: ИПП, «Кларитромицин» ("Clarithromycin"), «Амоксициллин» ("Amoxicillin") или «Метронидазол» ("Metronidazole").
Для того чтобы усилить эту стандартную тройную терапию, есть определенные методы. Российская гастроэнтерологическая ассоциация четко эти методы перечисляет. Например, это повышение приверженности пациента к проведению эрадикационной терапии.
Но есть еще одна методика, которая здесь обозначена восклицательным знаком. Это добавление препарата висмута (висмута трикалия дицитрата, «Де-Нола» в дозе 240 мг 2 раза в сутки) к стандартной тройной эрадикационной терапии.
Такой путь, безусловно, позволяет повысить процент эрадикации даже при наличии штаммов, резистентных к «Метронидазолу» и «Амоксициллину».
Безусловно, квадротерапия с препаратом висмута всегда является золотым стандартом проведения эрадикационной терапии. Она выказывает высокий процент уничтожение пилорического хеликобактера.
Вы видите, что даже по критерию (неразборчиво, 15:50) этот процент превосходит 90%.
Наконец, кроме эрадикации пилорического хеликобактера, как мы можем вести пациентов с гастритом, с точки зрения Российской гастроэнтерологической ассоциации.
Аутоиммунный атрофический гастрит выделен здесь специально.
Мы действительно проводим лечение витамином В12. Мы назначаем эрадикационную терапию при этой нозологической форме.
Но мы еще говорим о том, что возможно проведение долечивания после курса эрадикационной терапии с помощью «Висмута трикалия дицитрата» ("Bismuthate tripotassium dicitrate"). Этот препарат хорош не только для того, чтобы усилить эффективность эрадикационной терапии инфекции пилорического хеликобактера. Он обладает свойствами защиты слизистой оболочки. Это позволяет успешно назначать его, в том числе, и при аутоиммунном гастрите.
Хронический атрофический гастрит: современные представления и реальные возможности лечения больных

Хронический атрофический гастрит (ХАГ) – мультифакторное заболевание, которое характеризуется прогрессирующим развитием атрофических изменений слизистой оболочки желудка (СОЖ) с уменьшением количества желез. ХАГ представляет собой предраковое состояние, наличие которого значимо повышает риск последующего развития у пациента рака желудка (РЖ). Согласно действующей Сиднейской системе классификации гастрита (Sydney System Classification, впервые предложена в 1990 г., обновлена в 1994 г.), ставшей первой с момента открытия в 1982 г. Helicobacter pylori (H. pylori) подробной классификационной системой данного заболевания, выделяют 2 основные формы ХАГ: мультифокальный атрофический гастрит и аутоиммунный атрофический гастрит.
Считается, что аутоиммунный атрофический гастрит обусловлен образованием аутоантител к париетальным клеткам и поражает преимущественно тело желудка, а развитие мультифокального атрофического гастрита ассоциировано с H. pylori, вредным воздействием различных экзогенных факторов и особенностями питания. Установлено, что ключевой и универсальной гистологической характеристикой обеих указанных форм ХАГ является метаплазия СОЖ. Поэтому в настоящее время для их обозначения рекомендуется использовать общий термин «метапластический»: аутоиммунный метапластический атрофический гастрит и экзогенный мультифокальный метапластический атрофический гастрит.
Именно метаплазия (преимущественно кишечная), выявляемая в биоптатах СОЖ, взятых у пациентов с ХАГ, высокорелевантна в плане как патогенеза этого заболевания, так и его осложнений (таких как пернициозная анемия, дисплазия и РЖ). Последовательность событий, с течением времени приводящих к развитию аденокарциномы желудка (нормальная слизистая оболочка → атрофический гастрит → кишечная метаплазия (КМ) → дисплазия → аденокарцинома кишечного типа), была описана P. Correa еще в 1988 г. и хорошо известна как каскад Корреа.
Учитывая значение ХАГ как предракового состояния, становится очевидным, почему с момента установления этого факта и до настоящего времени не ослабевает интерес, проявляемый учеными и клиницистами к возможностям профилактики и лечения данного заболевания. Так, в ходе проведенного Y.S. Park и соавт. в 2008 г. многоцентрового проспективного клинического исследования с участием 389 человек была предпринята попытка установить факторы риска развития ХАГ и КМ. Анализ полученных результатов убедительно подтвердил, что наиболее важными общими факторами риска развития ХАГ и КМ выступают инфекция H. pylori и возраст (≥61 года).
Важнейшими факторами риска развития ХАГ оказалась вирулентность H. pylori (положительный результат анализа на наличие антигенов СagA и VacA), а также локализация H. pylori в антруме и теле желудка. В развитии КМ, помимо инфицирования H. pylori и пожилого возраста, значимую роль играло употребление очень острой пищи, курение в анамнезе, а также повышение уровня провоспалительных факторов, в частности интерлейкина (IL)-10-592. Примечательно, что IL6-572 G, напротив, характеризовался протективными свойствами в плане развития КМ.
Особенности патогенеза ХАГ и прогнозирование канцерогенеза
С позиций патогенеза выделяют 2 основных пути формирования атрофии СОЖ:
1) непосредственная деструкция железистого аппарата желудка или деструкция на фоне хронического воспаления;
2) избирательная деструкция специализированных эпителиоцитов в условиях сохранения стволовых клеток, триггерами которой выступают инфекция H. pylori, аутоиммунные реакции, химические и медикаментозные воздействия (в том числе желчные кислоты – ЖК, нестероидные противовоспалительные препараты – НПВП) и др.
В последнее время все большее значение придается синергичному воздействию различных факторов, способных повреждать СОЖ, и в первую очередь – сочетанному пагубному воздействию на нее H. pylori и ЖК.
Так, под воздействием бактериальной фосфолипазы H. pylori ослабевают гидрофобные защитные свойства желудочной слизи и уменьшается толщина слизистого слоя, что облегчает реализацию прямого повреждающего действия на слизистую оболочку ЖК и других химических факторов. При этом повреждающий эффект ЖК зависит от их концентрации, конъюгации и значения интрагастрального рН: в кислой среде СОЖ активно повреждают тауриновые конъюгаты ЖК, в нейтральной и слабощелочной – неконъюгированные ЖК. Кроме того, при наличии в желудке желчи усиливается агрессивность таких «классических» повреждающих агентов, как НПВП, ацетилсалициловая кислота и факторы патогенности H. pylori.
Что же касается риска канцерогенеза, то к сожалению, Сиднейская система классификации гастритов и гастропатий, несмотря на широкое использование в клинической практике, не дает возможности его прогнозировать. В этом контексте существенным шагом вперед стало появление в 2008 г. классификационной шкалы OLGA (Operative Link for Gastritis Assessment), учитывающей степень атрофических изменений СОЖ (от отсутствия до тяжелой атрофии), их локализацию (антрум, тело желудка) и на основании этого выделяющей гистологические фенотипы для прогнозирования низкого либо высокого риска канцерогенеза.
Профилактические и терапевтические стратегии
Ключевая цель профилактики и лечения ХАГ и КМ – снижение распространенности РЖ в популяции. Поскольку доказано, что ключевым этиопатогенетическим фактором развития данных предраковых состояний выступает инфекция H. pylori, ни у кого не вызывает сомнений, что основной стратегией профилактики РЖ должна быть ее эрадикация. Вместе с тем комплексный подход к ведению пациентов с ХАГ и КМ предусматривает также выявление и коррекцию других вышеупомянутых триггеров и факторов риска (C.A.Gonzales, A. Agudo et al., 2012).
Результаты некоторых исследований свидетельствуют о том, что эрадикация H. pylori до формирования КМ может быть эффективна в снижении риска развития РЖ (J.G. Fox, T.C. Wang, 2001), однако вопрос о том, насколько она способна повлиять на естественное течение уже имеющейся КМ, остается открытым. Результаты длительного (6-7 лет) наблюдения за пациентами с ХАГ тела желудка и КМ (n=179/106 соответственно; E. Lahner et al., 2005) показали, что в течение этого периода атрофия слизистой оболочки тела желудка и КМ продолжали персистировать независимо от наличия инфекции H. pylori.
При этом у 8% пациентов развились неопластические изменения (Р <0,0001). В более поздних исследованиях (2010) было установлено, что через год после эрадикации H. pylori восстановление СОЖ было достигнуто лишь у 13,3% пролеченных пациентов, частичное регрессирование воспалительных изменений – у 58,6%. При этом у 28,2% пациентов сохранялось исходное воспаление – этот факт авторы связали с повышенной активностью ферментов циклоокисгеназы (ЦОГ) и индуцируемой синтазы оксида азота.

Рис. 1. Морфологические изменения СОЖ в процессе канцерогенеза (M. Dinis-Ribeiro et al., 2012)
A, B – неатрофический гастрит без атрофии желез и/или КМ: (A) антрального отдела (окрашивание гематоксилином и эозином ×40); (B) тела желудка (окрашивание гематоксилином и эозином, ×100). C, D – умеренная атрофия глубоких антральных желез (уменьшение количества желез на 30-60%) без КМ: (C) окрашивание гематоксилином и эозином, ×40; (D) реактив Шиффа – окрашивание альциановым синим (×40), выявляющее утрату желез и наличие единичного фокуса КМ в поверхностной части СОЖ. E, F – тяжелая атрофия слизистой оболочки антрального отдела желудка с утратой более чем 60% изначального количества секретирующих слизь желез, замещенных КМ: (E) окрашивание гематоксилином и эозином, ×40; (F) реактив Шиффа – окрашивание альциановым синим, ×40. G, H – дисплазия и внутрислизистая карцинома: (G) низкая степень дисплазии слева и высокая – справа (окрашивание гематоксилином и эозином, ×100); (H) внутрислизистая карцинома (окрашивание гематоксилином и эозином, ×200).
В 2012 г. в журнале Endoscopy M. Dinis-Ribeiro и соавт. были опубликованы Рекомендации по ведению предраковых состояний и повреждений слизистой оболочки желудка (MAPS), разработанные экспертами Европейского общества гастроинтестинальной эндоскопии (ESGE), Европейской группы по изучению H. pylori (EHSG), Европейского общества патологии (ESP) и Португальского общества эндоскопических исследований желудочно-кишечного тракта (SPED).
В этом документе подчеркивается, что ХАГ, КМ и дисплазия желудочного эпителия (рис. 1) отмечаются достаточно часто и несомненно ассоциированы с повышенным риском РЖ. Поэтому в случае их выявления необходимо адекватное установление точной стадии патологического процесса, а также динамическое клинико-лабораторно-инструментальное наблюдение за пациентами в соответствии с предложенным экспертами алгоритмом (рис. 2).

Рис. 2. Алгоритм ведения пациентов с предраковыми состояниями и повреждениями слизистой оболочки желудка (MAPS)
В соответствии с данными рекомендациями эрадикация H. pylori способствует излечению хронического неатрофического гастрита и может приводить к частичному регрессированию ХАГ (уровень доказательности I+, класс рекомендации В). Как указывается в рекомендациях, хотя эрадикация H. pylori у пациентов с КМ и не вызывает ее обратного развития, она может замедлять прогрессирование неоплазии и следовательно все равно настоятельно рекомендуется (уровень доказательности I+, класс рекомендации В). Эрадикация H. pylori также показана пациентам с предшествующей неоплазией после эндоскопического либо хирургического лечения (уровень доказательности I++, класс рекомендации А).
В данных рекомендациях также освещены дополнительные меры, которые могут быть использованы в ведении пациентов с предраковыми состояниями желудка. Так, по мнению экспертов, в настоящее время пока не может быть утверждено применение ингибиторов ЦОГ‑2 с целью снижения риска прогрессирования предраковых изменений СОЖ (уровень доказательности I+, класс рекомендации В). На момент принятия рекомендаций экспертами также не поддерживалось использование диетических добавок на основе антиоксидантов (аскорбиновая кислота и бета-каротин) в качестве средств для уменьшения распространенности атрофии и КМ (уровень доказательности I+, класс рекомендации В).
Вместе с тем контроль других факторов риска, не связанных с инфекцией H. pylori, рассматривается в качестве перспективного и активно изучающегося подхода, который в будущем способен повлиять на кумулятивную частоту развития РЖ. С этой целью продолжаются исследования потенциального профилактического эффекта адекватного потребления свежих овощей и фруктов. Следует отметить, что положительное антиоксидантное влияние витамина С, фолиевой кислоты и бета-каротина уже было установлено в некоторых ранее проведенных исследованиях (P. Correa, E.T. Fantham et al., 2000), хотя и не подтверждено в выполненных к настоящему времени метаанализах. Высказывается предположение, что дополнительные преимущества пациентам с ХАГ и КМ может принести подход, включающий сочетание эрадикации H. pylori с соблюдением определенных диетологических рекомендаций и употреблением пищевых добавок (G. Bjelakovic, D. Nikolova et al., 2004).
Особого внимания заслуживает возможность применения у пациентов с ХАГ мукоцитопротекторов – препаратов, способных уменьшать либо устранять повреждения слизистой оболочки гастродуоденальной зоны, вызванные различными воздействиями. В качестве оптимальных мукоцитопротекторов для пациентов с ХАГ в настоящее время могут рассматриваться висмута субцитрат коллоидный и урсодезоксихолевая кислота (УДХК, Урсохол ® ).
Висмута субцитрат коллоидный обладает антибактериальным действием, повышает эффективность эрадикации, обеспечивает противовоспалительный эффект, частично связывает ЖК, проявляет антиоксидантное действие, что способствует уменьшению экспрессии онкогенов (А.В. Яковенко и соавт., 2006; А.В. Кононов и соавт., 2011; В.Т. Ивашкин и соавт., 2014). Назначение УДХК (Урсохол ® ) обеспечивает влияние на одну из основных не связанных с H. pylori причин, поддерживающих хроническое воспаление в СОЖ, – агрессивное воздействие ЖК, что особенно актуально у пациентов с дуоденогастральным рефлюксом и рефлюкс-гастритом. УДХК вытесняет токсичные ЖК, делая рефлюктат менее агрессивным, и встраивается в фосфолипидный слой мембран, повышая его устойчивость к повреждающим факторам. Терапия УДХК предотвращает индуцированный гидрофобными ЖК апоптоз, снижает литогенность желчи и обеспечивает улучшение ее эвакуации из желчного пузыря.
Учитывая длительность курсов приема УДХК, немаловажное значение для пациентов приобретает стоимость препарата, которая, безусловно, не должна становиться препятствием для эффективного и современного лечения. В клинической практике хорошо зарекомендовал себя отечественный препарат УДХК Урсохол ® (ЧАО «Фармацевтическая фирма «Дарница»), выпускаемый в форме капсул по 250 мг и имеющий наиболее доступную (в сравнении с зарубежными препаратами УДХК) стоимость.
Применение препарата Урсохол ® в комплексной терапии у пациентов с ХАГ/КМ после эрадикации H. pylori дает возможность на практике реализовать индивидуальный подход к коррекции ключевых факторов риска, способствующих поддержанию хронического воспаления в СОЖ и повышению риска малигнизации, а именно – нивелировать агрессивное воздействие ЖК и обеспечить мукоцитопротекцию.
Список литературы находится в редакции.
Тематичний номер «Гастроентерологія. Гепатологія. Колопроктологія» № 2 (48), травень 2018 р.
СТАТТІ ЗА ТЕМОЮ Гастроентерологія
Згідно із сучасним уявленням, диспепсія – це будь-який серединний епігастральний біль / печіння / дискомфорт, відчуття переповнення після вживання їжі / раннього насичення / відрижки, а також печія, нудота/блювання, здуття в епігастрії, що свідчать про залучення верхніх відділів шлунково-кишкового тракту та тривають не менше 4 тиж [1]. Диспепсію слід трактувати двома способами – і як синдром (вторинна диспепсія внаслідок основного захворювання), і як самостійну нозологічну форму (функціональна диспепсія, ФД) [2]. Систематичні огляди свідчать, що симптоми диспепсії в усьому світі мають ≈20-25% населення; в різних країнах вони є причиною до 10% усіх звернень по медичну допомогу [3, 4].
Щороку в світі реєструються близько 1,5 млрд випадків гострої діареї, яка є причиною загибелі >2 млн людей, причому в структурі летальності від діареї переважають діти перших 5 років життя. Високий рівень захворюваності та смертності, надзвичайне різноманіття етіологічних збудників гострої діареї значно ускладнюють обрання тактики дії та підбір адекватного лікування в умовах первинної медичної практики.
Під час науково-практичної конференції «Сучасні проблеми медицини», що відбулася в онлайн-форматі, доктор медичних наук, професор Андрій Едуардович Дорофєєв (Національний університет охорони здоров’я України ім. П.Л. Шупика, м. Київ) висвітлив питання уражень кишечнику в умовах пандемії коронавірусної хвороби (COVID‑19). У цьому матеріалі представлено виступ Андрія Едуардовича у форматі «запитання – відповідь».
Належне травлення є важливим фактором здоров’я та добробуту людини. Оскільки великі частинки їжі не можуть потрапити до клітин, процес травлення готує їжу для використання клітинами, розщеплюючи її на поживні речовини, які можуть усмоктуватися в кров і потрапляти до клітин. Ефективне травлення – це складний та багатоетапний процес, що включає механічне і ферментативне розщеплення їжі. Механічне травлення – фізичне розщеплення харчових речовин на дрібніші частинки для ефективнішого хімічного. Роль хімічного травлення полягає у подальшому спрощенні травними ферментами молекулярної структури харчових субстратів, основними з котрих є жири, складні вуглеводи та протеїни.
Аутоиммунный метапластический атрофический гастрит
Аутоиммунный метапластический атрофический гастрит – это наследственное аутоиммунное заболевание, поражающее париетальные клетки, что приводит к гипохлоргидрии и сниженной продукции внутреннего фактора. Последствия включают атрофический гастрит, мальабсорбцию витамина B12 и часто пернициозную анемию. При этом риск аденокарциномы желудка возрастает в 3 раза. Для диагноза необходима эндсокопия. Лечение проводится парентеральным введением витамина B12.
Этиология
У больных с аутоиммунным метапластическим атрофическим гастритом (АМАГ) выявляют антитела к париетальным клеткам и их составляющим (включая внутренний фактор и протонную помпу Н + -, К + -АТФазу). Аутоиммунный метапластический атрофический гастрит наследуется аутосомно-доминантным путем.
У некоторых больных аутоиммунный метапластический атрофический гастрит ассоциирован с хронической инфекцией Helicobacter pylori Инфекция Helicobacter pylori Helicobacter pylori – это широко распространенный возбудитель инфекции желудка, который вызывает такие патологии, как гастрит, язвенную болезнь, аденокарциному и низкодифференцируемую. Прочитайте дополнительные сведения , взаимоотношение которых неясно. Гастрэктомия и длительное подавление кислотной продукции ингибиторами протонной помпы вызывают сходный дефицит секреции внутреннего фактора.
Осложнения
Осложнения АМАГ включают:
Недостаточность витамина B12
Недостаток внутреннего фактора ведет к дефициту витамина В12 Недостаточность витамина B12 Алиментарный дефицит витамина В12 обычно является результатом недостаточного усвоения, но может развиваться и у вегетарианцев, которые не принимают витаминные добавки. Дефицит вызывает мегалобластную. Прочитайте дополнительные сведения , что может приводить к мегалобластной анемии Мегалобластные макроцитарные анемии Мегалобластные анемии чаще всего являются следствием дефицита витамина B12 и фолата. Неэффективный гемопоэз оказывает влияние на все клеточные ростки, но в особенности на эритроидный. Диагностика. Прочитайте дополнительные сведения
Зоны атрофического гастрита в теле и фундальном отделе могут проявится как метаплазия. Относительный риск развития аденокарциномы желудка Рак желудка Этиология рака желудка рассматривается как многофакторная, при этом показана важная роль Helicobacter pylori. Проявления болезни включают чувство раннего насыщения, нарушение проходимости. Прочитайте дополнительные сведения у больных аутоиммунным метапластическим атрофическим гастритом повышен в 3 раза.
Пациенты с атрофией желез и/или мультифокальной кишечной метаплазией, распространение которых включает участки малой кривизны и дна желудка, имеют фенотип, называемый мультифокальным атрофическим гастритом. Мультифокальное поражение считается «обширным», в отличие от «выраженного», которое указывает на тяжесть в конкретной локализации. Риск аденокарциномы желудка выше у пациентов с мультифокальным атрофическим гастритом.
Клинические проявления
Симптомы при манифестации аутоиммунного метапластического атрофического гастрита (AMAG) сами по себе немногочисленны и неспецифичны, хотя у некоторых пациентов отмечается дискомфорт в верхних отделах живота.
Степень проявления симптомов и признаков дефицита B12 Клинические проявления Алиментарный дефицит витамина В12 обычно является результатом недостаточного усвоения, но может развиваться и у вегетарианцев, которые не принимают витаминные добавки. Дефицит вызывает мегалобластную. Прочитайте дополнительные сведения вначале может быть минимальной, поскольку анемия развивается медленно, но в конечном итоге возникают усталость и слабость. Неврологические проявления возникают независимо от анемии, но, как правило, начинаются со снижения позиционной и вибрационной чувствительности в конечностях, что сопровождается слабой и умеренной слабостью и гипорефлексией.
Диагностика
Не существует специфических симптомов, указывающих на это расстройство. Оно чаще всего обнаруживается, когда пациентам проводят эндоскопию для оценки дискомфорта в верхних отделах живота или необъяснимой анемии. Эндоскопическая биопсия подтверждает диагноз. Необходимо оценивать уровень сывороточного B12. Обычно присутствуют антитела к париетальным клеткам, но рутинно их не измеряют.
Американская ассоциация гастроэнтерологов в Руководстве по ведению пациентов с кишечной метаплазией желудка от 2020 года (2020 guidelines on management of gastric intestinal metaplasia) рекомендует обследование и лечение H. pylori у пациентов с кишечной метаплазией желудка В этом американском руководстве пациентам с аутоиммунным метапластическим атрофическим гастритом и кишечной метаплазией желудка рутинное эндоскопическое наблюдение также не рекомендуется. Пациенты с атрофическим гастритом и кишечной метаплазией желудка, у которых повышен риск развития рака желудка, могут выбрать только наблюдение, но они должны отдавать себе отчёт в том, что просто наблюдение не приносит большой пользы, а проведение повторных эндоскопических исследований верхних отделов пищеварительного тракта имеет потенциально неблагоприятные последствия. Факторы, повышающие риск развития рака желудка, включают:
Семейный анамнез рака желудка
Иммиграция из регионов с высокой заболеваемостью раком желудка, таких как Корея, Япония и Южная Америка
Регулярное повторное проведение эндоскопии и биопсии с коротким интервалом (в течение 1 года) не рекомендуется, за исключением тех случаев, когда первичная эндоскопия была проведена неадекватно или показала нахождение в группе высокого риска по результатам гистологического исследования, либо если пациент находится в группе риска по раку желудка. Опять же, решение повторить эндоскопию в течение 1 года должно быть принято после того, как пациенты поймут низкую ценность наблюдения и потенциальные побочные эффекты повторных эндоскопических исследований. Если при совместном принятии решений и врач, и пациент склоняются к наблюдению, может быть целесообразным более длительный интервал (каждые 3–5 лет) эндоскопического наблюдения среди пациентов со случайно обнаруженной кишечной метаплазией желудка.
В обновленном в 2019 году руководстве по ведению пациентов с предраковыми состояниями и поражениями эпителия желудка 2019 update of the guidelines on management of epithelial precancerous conditions and lesions in the stomach Европейского общества желудочно-кишечной эндоскопии (ESGE), Европейской группы по изучению Helicobacter и микробиоты (EHMSG), Европейского общества патологии (ESP) и Португальского общества эндоскопии пищеварительного тракта (SPED) подчеркивается эффективность эндоскопии высокого разрешения с хромоэндоскопией при проведении эндоскопического обследования у таких пациентов.
Читайте также:
